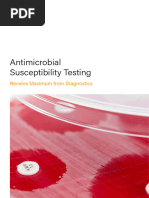

Phytochemical Screening and Antimicrobial Activity of Four Nigerian Medicinal Plants
Uploaded by
IonicPhytochemical Screening and Antimicrobial Activity of Four Nigerian Medicinal Plants
Uploaded by
IonicInternational Journal of Research in Pharmacy and Biosciences
Volume 5, Issue 2, 2018, PP 15-27
ISSN 2394-5885 (Print) & ISSN 2394-5893 (Online)
Phytochemical Screening and Antimicrobial Activity of Four
Nigerian Medicinal Plants
Nduche M.U, Egbucha K.C and Amakwe O. C
Department of plant Science and Biotechnology, Michael Okpara University of Agriculture, Umudike,
P. M. B 7267 Umuahia Abia State, Nigeria
*Corresponding Author: Nduche M.U, Department of plant Science and Biotechnology, Michael
Okpara University of Agriculture, Umudike, P. M. B 7267 Umuahia Abia State, Nigeria
ABSTRACT
Phytochemical screening and anti-microbial activity of Piper guineense Schum, Gongronema latifolium
Benth, Terminalia catappa L. and Psidium guajava L. were performed. The alkaloid content of the plant
species varied from 0.46±0.05 to 1.39%±0.03. The plants had more alkaloids than any other phytochemical
studied. The saponin content of the plant species ranged from 0.31±0.01 to 0.67±0.02%. The tannin content
of the plant species ranged from 0.13±0.00 to 0.37±0.00%. The phenol content of the plant species varied
from 0.37±0.00 to 1.66%±0.00 and was highest in G. latifolium (1.66±0.00). There was a moderate
distribution of saponin, tannin and flavonoid in the plant species. The flavonoid content of the plant species
ranged from 0.23±0.03 to 0.55±0.01. The microorganisms considered were: Candida albicans, Klebsiella
pneumonia, E. coli and Bacillus subtilis. Apart from K. pneumonia, P. guajava showed the highest
diameter of inhibition for all the microorganisms considered. The diameter of inhibition was least in
T.catappa for all the microorganisms studied while G. latifolium showed the highest diameter of inhibition
for all the clinical isolates investigated. The minimum inhibition concentration was between 100 mg/ml and
200 mg/ml against all the microorganisms. There were variations in the lowest concentrations of the
various plant extracts that inhibited the different clinical isolates.
Keywords: Phytochemical, anti-microbial, plant extracts, Nigerian plants.
INTRODUCTION counterparts thus rendering enormous
therapeutic benefits at an economical treatment
Over the years, plant extracts and plant-derived rate.
medicines have made immense contributions to
the overall health and well-being of human P. guineense ‘Uziza’ is of the family of
beings (Anyanwu and Nwosu 2014).The Piperaceae and contains over 700 species all
antimicrobial ability of plant extracts and oils over the world. According to Dada et al., (2013)
has established a platform for the processing and Piper. guineensis ‘Uziza’ is a local spice that
transformation of these plant products into comprises of dillapiol, 5-8% of piperine,
pharmaceuticals, preservatives and natural elemicine, 10% of myristicine and safrole and
medicine. these chemicals exhibit bactericidal and
From time immemorial, the use of plants for the antimicrobial effects on certain microorganisms.
treatment of diseases has been widely accepted These effects have been associated with the
due to their healing properties. According to presence of phytonutrients such as flavonoids,
World Health Organization, many micro alkaloids, glycosides, essential oils, tannins,
organisms are developing resistance to several saponins, peptides and phenols in this
drugs which is posing severe threat to the spectacular plant.
general public health hence requires actions Sumathykutty et al. (1999) agree that P.
across all sectors to curb this menace. guineense ‘Uziza’ leaves are aseptic in nature,
As a result of this, there is a growing interest in with the ability to relieve flatulence. They are
plant’s usage for medicinal purposes due to the also useful for treating intestinal diseases,
presence of several antibacterial compounds cough, bronchitis and rheumatism. According to
present in them. (Cowan, 1999), Bruneton the research carried out by Nwachukwu et
(1999) agree that medicines developed from al.(2010) on the uses of some medicinal plants,
plants are comparably safer than their synthetic they found out that Piper guineense ‘Uziza’ is
International Journal of Research in Pharmacy and Biosciences V5 ● I2● 2018 15
Phytochemical Screening and Antimicrobial Activity of Four Nigerian Medicinal Plants
suitable for treating Infertility in women & Low taken to treat diabetes and high blood pressure.
sperm count in men. The latex is applied to teeth affected by caries. It
is also taken for controlling weight gain in
The authors agreed that women with infertility
lactating women and overall health
problems should boil Piper guineense ‘Uziza’
management. Asthma patients chew fresh leaves
together with Xylopia spp (Uda), lime juice,
to relieve wheezing. A cold maceration of the
Honey, Gongronema latifolium (utazi) and
roots is also taken as a remedy for asthma. A
Capsicum spp pepper in 1 liter. of water and
decoction of the roots, combined with other
then take 1 glass cup on a daily basis only
plant species, is taken to treat sickle cell
during menstruation (for women). Men on the
anaemia. A maceration of the leaves in alcohol
other hand, can take ½ bottle of lime juice
is taken to treat bilharzia, viral hepatitis and as a
mixed with 1 bottle of honey and taken 1 shot
general antimicrobial agent (Okeke et al.2008,
twice on a daily basis for low sperm count
Oshinubi and Awodele 2006).
treatment
Gangronema latifolium (utazi) is a climbing
According to Ashok and Upadhyaya (2012)
shrub with broad, heart-shaped leaves that has a
tannins are phenolic compounds with proline-
rich proteins that helps to inhibit the absorption characteristic sharp, bitter and slightly sweet
of iron when present in the gastro-intestinal taste, especially when eaten fresh. The stems
lumen. have soft/hairy that yields milky latex or
exudates.
This thus reduces the bio-availability of iron due
to the presence of anti-hemorrhoidal, anti- It belongs to the family of plants known as
diarrheal and haemostatic compounds that helps Asclepiadaceae and it is widespread in tropical
to treat diseases such as irritating bowel rainforest of West African countries, such as
disorders, enteritis, gastritis and esophagitis. Nigeria, Côte d’Ivoire, Sierra Leone, Ghana and
Piper guineense is part of the plants and herbs Senegal, etc.
categories that contain tannins as their primary In southern Nigeria, where it is commonly
components thus are known as astringent. grown, the Igbos call the plant utazi, the Yoruba
Because of its astringent properties, the Piper know it as arokeke and the Efik and Ibibio call it
guineense is highly beneficial for treating utasi. Parts used Fruits, seeds, leave, root and
intestinal disorders such as diarrhea and bark(Edet et al.2005).
dysentery, healing of wounds and inflammation
of mucous membrane. Chemical constituents such as, essential oils,
alkaloids, saponins and tannin, various minerals,
Alkaloids which are natural product present in vitamins and some essential amino acids.
P. guineense ‘Uziza’ are made up of
heterocyclic nitrogen that possess antimalarial, Experience has shown that the whole plant
pharmacological, anti-hypertensive, anti-arrhy exhibits the following herbal actions- analgesic,
thmic and anticancer effect (Mamta et al. 2013). antitumor, broad spectrum anti microbial
Flavonoids on the other hands, are remarkable (antibacterial, antifungal, anti parasitic and
for their countless health benefits to human antiviral), antipyretic, antioxidant, anti-
beings, especially due to their antiplatelet, inflammatory, antiulcer, anti-sickling, anti-
antiviral, anti-tumor, anti-allergic, anti-oxidant asthmatic, mild expectorant, hypoglycemic,
and anti-inflammatory abilities (Pal and Verma hypolipidemic, hepatoprotective, digestive tonic
2013) and laxative properties(Eleyinmi 2007).
Gongronema latifolium is widely used in West The fresh leaves or the stem can be chewed or
Africa for medicinal and nutritional purposes. the sap extracted with water or palm wine. The
An infusion of the aerial parts is taken to treat whole plant can equally be infused with boiling
cough, intestinal worms, dysentery, dyspepsia water (as tea) or by boiling (decoction).
and malaria. It is also taken as a tonic to treat
loss of appetite. In Sierra Leone an infusion or In some cases, the dried or fresh leaves are
decoction of the stems with lime juice is taken prepared as tincture (i.e. extraction in alcoholic
as a purge to treat colic and stomach-ache. In beverages). Like most bitter-tasting herbs,
Senegal and Ghana the leaves are rubbed on the bitter-tasting herbs, Gangronema latifolium
joints of small children to help them walk. The contains “Bitter principles” (a combination of
boiled fruits in soup are eaten as a laxative. A alkaloids, glycosides, tannins, essential oils,
decoction of leaves or leafy stems is commonly etc).
16 International Journal of Research in Pharmacy and Biosciences V5 ● I2 ● 2018
Phytochemical Screening and Antimicrobial Activity of Four Nigerian Medicinal Plants
Generally speaking, bitter-tasting herbs, such as Gongronema latifolium, is a tropical rainforest
bitter leaf, utazi, phyllanthus, etc. are known to plant primarily used as spice and vegetable in
act as stimulating tonics for the digestive traditional folk medicine (Ugochukwu and
system. Babady 2002, Ugochukwu et al.2003).Reports
by various authors showed that it contains
They stimulate the flow of bile and appetite for essential oils, saponins and pregnanes among
food and they enhance the activities of the others (Schneider et al.1993, Morebise and
pancreas, regulate blood sugar and promote the Fafunso 1998, Morebise et al.2002). Ogundipe
detoxification actions of the liver (Ugochukwu et al. (2003) reported that aqueous and ethanolic
and Babady 2003, Ugochukwu and Cobourne G. latifolium extracts had hypoglycemic, hypo
2003). lipidemic and antioxidative properties while
In southern part of Nigeria, especially among Morebise et al. (2002) showed that it has anti-
the people of Southeast and South-South, the inflammatory properties. These reports are
focused mainly on the medicinal properties of
leaves of this herb are used commonly for
the plant with little attempts at investigating
nutritional purposes, including as a spice and
their potential nutritional and food
vegetable to garnish some special local
processing/preservation values
delicacies, such as Isiewu, nkwobi, abacha/ugba
(African salad) ofe nsala (white soup), unripe Terminalia catappa is a native, fast-growing,
plantain porridge, etc because of its sharp-bitter deciduous tree with a pagoda-like crown with
and sweet taste. layers of branches spaced at about 1–2 m apart.
They can grow up to 25 m tall.
The leaves are believed to neutralise the
intoxicating properties alcohol and its harmful The spirally arranged leaves are egg-shaped
effects on the liver. An infusion or decoction of with the narrower end towards the leaf stalk.
the whole plant (the leaves and stems) is used in Being a naturally coastal plant, they have leaves
the home treatment of: Digestive problems, such that are leathery and glossy. The leaves are a
darker green on the top surface and a paler green
as loss of appetite, dyspepsia, colic and
on the bottom, but they do change colours
stomachache, constipation, dysentery and
seasonally. They will go from a dark red to
intestinal worms. yellow before being shed. New purplish foliage
Infused utazi leaves can be used as a home will follow. Shedding of the leaves takes place
remedy for dysentery and intestinal worms. twice a year. Flowers are tiny, foetid and
The leaves when chewed raw or infused with greenish-white, and are borne on spikes. The
hot water can act as a fast relief for catarrh, flowers have no petals. The fruit is almond-
congested chest, running nose and cough shaped, with a thin fleshy covering over a corky
(Essien et al.2007). stone (Chong et al.2009 and Tan 2011).
Lactating mothers can use utazi to control their The Sea Almond tree is found in tropical and
body weight as well as maintain a healthy body near-tropical regions, mostly in humid areas.
system. The utazi leaves can be macerated in This is a common species found on rocky and
alcohol and used for the treatment of viral sandy beaches, but in Singapore, it is also
hepatitis and bilharzia. The utazi fruits can be commonly cultivated along streets and in parks
used to cook soup, which can be eaten as a and gardens as a shade tree. It is however less
laxative. preferred for street planting because it sheds its
leaves twice yearly, making a mess.
Researchers agree that the decoction of the utazi
leaves or stems can be beneficial in treating high The fruit has a corky layer which makes it
blood pressure and diabetes. Infused utazi leaves buoyant for water dispersal. The seed can
are very helpful in treating malaria. remain viable for a long time even after being
The utazi latex from the fruits can be applied on dispersed by water for long distances. Bats are
the teeth that are affected by caries. also known to eat the fruits and disperse the
Sierra Leone infuses the utazi stems with lime seeds (Tan 2011).
juice before drinking it and this acts as a Its bark and leaves are sources of tannin or black
purgative to treat stomach ache and colic. dye for tanning leather or dyeing textiles,
People suffering from asthma can chew utazi respectively. Timber from the Sea Almond tree
leaves or macerated roots to help relieve them can be used for furniture, flooring and other
from wheezing (Essien et al.2007). wood works, however, it is susceptible to
International Journal of Research in Pharmacy and Biosciences V5 ● I2● 2018 17
Phytochemical Screening and Antimicrobial Activity of Four Nigerian Medicinal Plants
termites. It is a preferred wood for boats though antimicrobial, anti-inflammatory actions (Joseph
due to its durability in water. and Priya 2011, Rishika and Sharma 2012) and
guaijaverin known for its antibacterial action
The tannin has been used medicinally to treat
(Mittal et al. 2010). Pulp contains ascorbic acid,
rheumatism, headache, colic and diarrhea,
carotenoids (lycopenes, β-carotene) possessing
among other ailments. Crushed leaves put in a
antioxidant, anti-hyperglycemic, antineoplastic
bath can also relieve skin rash. The fruit flesh is
(Barbalho et al.2012) The seed contains
edible and so is the seed, which also yields an
glycosides, carotenoids, phenolic compounds
oil similar to almond oil. The kernel oil is also
having antimicrobial actions (Barbalho et al.
known to be able to relieve abdominal
2012)
inflammation. The fruits and seeds have also
been researched for its medical value in diabetic Guava is proven for its antidiarrheal,
treatment and for sexual dysfunctions in men, antimicrobial, antiparasitic, antitussive, hepato
respectively (Nagappa et al. 2003, Ratnasooriya protective, antioxidant, antigenotoxic, anti
and Dharmasiri 2000) mutagenic, antiallergic, anticancer and anti-
hyperglycemic effects (Gupta et al.2011).
Parts of the tree, such as the leaves and fruit, are
Acclaimed as the ‘poor man's apple of the
astringent. The leaves, crushed with Dacrydium
tropic’ (Kamath et al.2008) guava has been used
elatum and rhizomes of Cyperus rotundus, are
for various purposes in different regions of the
combined to treat dysentery. The red leaves act
world. It has been used in the treatment of
as a vermifuge, while the sap of young leaves,
diarrhea, dysentery, menstrual disorders,
cooked with oil from the kernel, is used to treat
vertigo, anorexia, digestive problems, gastric
leprosy. Leaves may be rubbed on breasts to
insufficiency, inflamed mucous membrane,
cure pain or, when heated, may be applied to
laryngitis, skin problems, ulcers, vaginal
numb parts of the body. They may be used as a
discharge, cold, cough, cerebral ailments,
dressing for swollen rheumatic joints. Leaves,
nephritis, jaundice, diabetes, malaria and
bark and fruit are used to treat yaws. The bark
rheumatism to mention a few (Kumar 2012,
and root bark are useful for bilious fever,
Joseph and Priya 2011).
diarrhoea, thrush, and as a remedy for sores and
abscesses. The kernel of the fruit mixed with All parts of the young fruit are astringent. Guava
beeswax stops putrid exudation and bloody exhibits antibacterial action against intestinal
faeces. It is recommended as a mild laxative and pathogens such as Staphyloccocus. The dried
a galactagogue for women, but too frequent use ripe fruits are recommended as a remedy for
causes diarrhoea. The young leaves are used to dysentery, while the leaves and fruits are used as
cure headaches and colic (Ratnasooriya and a cure for diarrhoea. Oil contains bisabolene and
Dharmasiri 2000) flavinoides that exhibit anti-inflammatory
Psidium guajava is a large dicotyledonous properties. A decoction of the leaves or bark is
shrub, or small evergreen tree, generally 3-10 m taken externally as a lotion for skin complaints,
high, many branches; stems crooked, bark light ringworm, wounds, and ulcers. Water from
to reddish brown, thin, smooth, continuously soaking the fruit is good to treat diabetes. The
flaking; root system generally superficial and leaves are made into a cataplasm; cooked, they
very extensive, frequently extending well are given to horses with strangle. Some
beyond the canopy, there are some deep roots suggested treatments are digestive tract
but no distinct taproot ailments, cold, and high blood pressure: leaf
decoction or fruit juice with salt or sugar taken
The important constituents of guava are orally. Trauma, pain, headache, and rheumatism:
vitamins, tannins, phenolic compounds, hot leaf decoction compress. Sore throat, hoarse
flavonoids, essential oils, sesquiterpene alcohols throat: leaf decoction, gargle. Varix, ulcer: leaf
and triterpenoid acids (Ugochukwu and
decoction, treated with warm water, bath.
Cobourne 2003).Leaves contain phenolic
Hepatitis, gonorrhoea, and diarrhoea: clear fruit
compounds, isoflavonoids, gallic acid, catechin,
juice.
epicatechin, rutin, naringenin, kaempferol
having hepatoprotective, antioxidant, anti- The paste of tender leaves of guava has been
inflammatory, antispasmodic, anticancer, anti traditionally used to maintain oral hygiene
microbial, anti-hyperglycemic, analgesic actions (Prabu et al. 2006) Guava has shown
(Ugochukwu and Cobourne 2003).The leaf antibacterial activity against both Gram-positive
contain two important flavonoids quercetin and Gram-negative bacteria (Ushimaru et
known for its spasmolytic, antioxidant, al.2007, Joseph et al.2010, Gashe et al. 2010).
18 International Journal of Research in Pharmacy and Biosciences V5 ● I2 ● 2018
Phytochemical Screening and Antimicrobial Activity of Four Nigerian Medicinal Plants
The antimicrobial activity of guava is mainly dilute ferric chloride solution. A greenish black
attributed to flavonoids, guaijaverin and precipitate was formed indicating the presence
quercetin (Prabu et al. 2006, Adeyemi et of tannins.
al.2009, Arima and Danno 2002, Metwally et al.
Test For The Presence Of Saponins
2010). The bark has exhibited antibacterial
properties due to the presence of tannins (Tona The presence of saponin in the samples was
et al.1994) determined by the method described by Obadoni
and Ochuku (2001). 2g of powdered sample was
MATERIALS AND METHOD mixed with 5ml of distilled water in a test tube.
Collection of Plant Materials and Identification The mixture was shaken vigorously. A stable
froth (foam) on standing indicates the presence
The fresh and healthy leaves of the plant of saponin. In the emulsion test, 3 drops of
species; Piper guineense, Gongrenema groundnut oil was added to 2g of sample and
latifolium, Terminalia catappa and Psidium was mixed with 5ml of distilled water and
guajava, were obtained from the premises of shaken well. Formation of emulsion indicates
Michael Okpara University of Agriculture the presence of saponin.
Umudike, Abia state. They were identified by
the taxonomic unit of the Department of Plant Test for the Presence of Flavonoids
science and Biotechnology Michael Okpara The presence of flavonoids in the samples was
University of agriculture, Umudike; Abia state. determined by the acid alkaline test method
Preparation of the Sample for Analysis described byTyler (1994). 2g of the plant
sample was put into test tube and a few drops of
The extraction of the plant leaves were carried concentrated ammonia solution added to it. A
out using known standard procedures. The plant yellow coloration was found which turned
samples were oven dried at for 5 hours. The colorless when few drops of concentrated
dried samples were milled using Thomas - hydrochloric acid gas added to it showing the
Willey milling machine and stored in the presence of flavonoid in the sample.
Central laboratory of National Root Crop
Research Institute, Umudike Abia State. 5g of Test for the Presence of Alkaloids
the leaf sample was measured out and placed in The presence of alkaloid in the test sample was
different conical flasks.100ml of water and carried out using the Mayer and Wagner test and
ethanol was poured in each leaf sample was described by Harborne (1988). 2g of the
respectively. It was left for 24hours before powdered sample was put into a conical flask
extracting the solution. The extracts were and 10 ml of absolute ethanol (98%) was added
filtered using Whatman filter paper (No 1) and into the flask. After shaking vigorously for
dried over a steam bath. The aqueous and about 30 minutes, it was filtered and the filtrate
ethanol extracts of the leaf sample yielded a was used as the extract. The formation of an
dark greenish residue. The extracts were orange coloration indicated the presence of
preserved for further investigation for potential alkaloids.
of anti-microbial properties. The extracts were Test for the Presence of Phenols
subjected to preliminary phytochemical testing
to detect the presence of different chemical The presence of phenols is determined by using
group of compounds. Air dried and powdered the method described by Harborne (1973). 2g of
plant materials were screened for the presence the sample was soaked to 10ml of methanol.
of saponins, tannins, alkaloids, flavonoids and After 24hours, it was filtered using Whatman
phenols. filter paper (No1). 2ml of the extract was mixed
with a dilute ferric chloride solution. A blue
Phytochemical Analysis green or black coloration was formed indicating
Qualitative Analysis on Leaf Extract the presence of phenols.
Test for the presence of Tannins Quantitative Analysis of Phytochemicals
The presence of tannins in the samples was Extracts were analyzed for the presence of
determined using the method described byVan- alkaloids, saponins, tannins and flavonoids
Burden and Robinson (1981). 2g of the sample according to Sofawara (1993), Trease and Evans
was soaked in 10 ml of methanol. After 24 (1989), Yadav and Agarwala, (2011). Using 2g
hours, it was filtered using what man filter paper of each sample, isolation and determination of
(No 1). 2ml of the extract was mixed with a phenolic compounds were carried out. Using the
International Journal of Research in Pharmacy and Biosciences V5 ● I2● 2018 19
Phytochemical Screening and Antimicrobial Activity of Four Nigerian Medicinal Plants
soxhlet apparatus for 2 hrs. The samples were were incubated at 370C for 24 hours before the
defatted with 100 ml of diethyl ether. The reading was taken on the area of growth
defatted samples were heated with 50 ml inhibition. Sensitivity of the organisms was
petroleum for the extraction of the compounds. recorded.
5 ml of the extract was pipetted into a 50 ml
flask for about 15 min and 10 ml of distilled Control Experiment Using Antibiotics
water was added to it. With addition of 5 ml In order to compare the diameter of zone of
amyl-alcohol and 20 ml of aqueous NH4OH inhibition from the extracts an already
solution, the complex color developed. This standardized antibiotic control experiment is
took place for about 30 min and the absorbance necessary and it was carried out aseptically.
read with a spectrophotometer. This is to encourage the prescription of either
antibiotics or the plant leaves with antimicrobial
Determination of Anti-Microbial Activity activities. The antibiotics used for the
Preparation of the Plant Extracts comparison is Gentamycin.
The ethanolic extracts of the leaves of Determination of Minimum Inhibitory
Gongrenema latifolium Piper guineense, Concentration
Psidium guajava, and Terminalia catappa were The Minimum Inhibitory Concentration (MIC)
prepared. 5g of the powdered leaf samples was is determined for the active plant extracts that
soaked in 100ml of ethanol and allowed to stand showed the widest spectrum of antimicrobial
for 24 -48 hours. The filtrate was evaporated to activity against test microorganisms.
dryness over steam bath. The residue was The MIC was considered the lowest
dissolved to obtain the desired plant extract for concentration of the sample that prevented
the anti-microbial test. visible growth. All samples were examined in
triplicate. Aliquiot of the extract 0.2 mg was
Sources of Pathogen
dissolved in 100ml of distilled water to obtain
Pathogen used in this study are Candida 2.0mg/ml. This concentration was then diluted
albican, Klebsiella pneumonia, Escherchia coli in sterile distilled water to obtain concentration
and Bacillus subtilis. They were obtained from of 200, 150, 100 and 50mg/ml.
the stock culture of the veterinary laboratory, Statistical Analysis
Michael Okpara University of Agriculture
Umudike Abia State. Viability test of each The data obtained is expressed as mean ±
isolate was carried out by resuscitating the standard error for the diameter of inhibition in
organism cultured in a nutrient agar medium and each group. The data obtained was analyzed by
incubated at 37°c for 24 hours. using the one way analysis of variance
(ANOVA) in all cases, statistical significance
Anti-Microbial Test was established at values (P < 0.05).
The sensitivity of the test organism to the
ethanolic and aqueous extract of Gongrenema
latifolium, Piper guineense, Psidium guajava,
and Terminalia catappa was carried out using
the disk diffusion technique.
The locally prepared sterile discs were soaked in
the water extract for some hours and 7g of
nutrient agar was dissolved in 250 ml of
distilled water and was sterilized using
autoclave and the nutrient agar medium was Plate1. The leaves of Piper guineenses
poured in sterile Petri dishes and it was allowed
to solidify. 1ml of the test organisms was placed
on the solidified agar and it was spread all over
the surface of the agar. The soaked discs was
placed into the different leaf extract and was
picked using sterile forceps and it was dropped
on the surface of the agar. Discs should be firm
having even contact with the surface of the
medium. At least three replications for each
bacterial strain are recommended. The plates Plate2. The leaves of Gongronema latifolium
20 International Journal of Research in Pharmacy and Biosciences V5 ● I2 ● 2018
Phytochemical Screening and Antimicrobial Activity of Four Nigerian Medicinal Plants
Plate3. The leaves of Terminilia catappa Plate4. The leaves of Psidium guajava
RESULTS
The result of the phytochemical screening of Piper guineenses, Gongronema latifolium, Terminalia
catappa and Psidium guajava presented in Table 1 and 2.
Table1. The qualitative analysis of Piper guineenses, Gongronema latifolium, Terminalia catappa and Psidum
guajava
Samples Alkaloid Saponin Tannin Phenol Flavonoid
P. guineenses + + + + +
G. latifolium ++ + + ++ +
T. catappa + + + + +
P. gujava ++ + + + +
Key: += Present
++= Highly present
All the plant species used for the research in varying proportion (Table 1).
contained saponins, tannins, flavonoid, alkaloid,
The quantitative estimation of the percentage
phenols in varying proportion (Table 1).
composition of the phytochemical in Piper
The quantitative estimation of the percentage guineenses, Gongronema latifolium, Terminalia
composition of the phytochemical in all the catappa and Psidium guajava are presented in
plant species used for the research contained Table 4.1.2 Quantitative analysis
saponins, tannins, flavonoid, alkaloids, phenols
Table2.The percentage yield of alkaloid, saponin, tannin, phenol and flavonoid of Piper guineenses,
Gongronema latifolium, Terminalia catappa and Psidium guajava
Samples Alkaloid Saponin Tannin Phenol Flavonoid
P. guineense 0.46a±0.05 0.31a±0.01 0.18b±0.00 0.37a±0.00 0.23a±0.03
G. latifolium 1.39c±0.03 0.52c±0.02 0.37d±0.00 1.66d±0.00 0.37b±0.11
T. catappa 0.47a±0.01 0.67d±0.02 0.13a±0.00 0.74b±0.00 0.55d±0.01
P. gujava 1.11b±0.02 0.43b±0.33 0.33c±0.00 0.79c±0.00 0.46c±0.02
The alkaloid content of the plant species varied 0.37±0.00 to 1.66%±0.00 and was highest in G.
from 0.46±0.05 to 1.39%±0.03. The plants had latifolium (1.66±0.00). There was a moderate
more alkaloids than any other phytochemical distribution of saponin, tannin and flavonoid in
studied. The saponin content of the plant species the plant species.
ranged from 0.31±0.01 to 0.67±0.02%.
The flavonoid content of the plant species
The tannin content of the plant species ranged ranged from 0.23±0.03 to 0.55±0.01. The
from 0.13±0.00 to 0.37±0.00%. The phenol amount of flavonoid was least in the plant
content of the plant species varied from species.
Table3. Antimicrobial activity of Aqueous and Ethanolic extract of Piper guineenses, Gongronema latifolium,
Teminalia catappa and Psidium guajava
Bacillus
Samples Organism/Extract Candida albicans Klebsiella pneumonia E. coli
subtilis
P. guinseense Aqueous 10.33b±1.15 11.67b±0.58 14.67b±1.15 12.33a±1.15
International Journal of Research in Pharmacy and Biosciences V5 ● I2● 2018 21
Phytochemical Screening and Antimicrobial Activity of Four Nigerian Medicinal Plants
Ethanolic 13.67cde±1.15 14.67c±0.58 20.00d±1.74 17.32b±1.15
G. latifolium Aqueous 12.33c±1.15 15.67c±2.52 13.67b±1.15 12.67a±0.58
Ethanolic 15.33c±1.15 24.00c±2.00 22.33e±1.53 19.33c±1.53
T. catappa Aqueous 8.33a±0.58 8.67a±0.58 11.33a±0.58 11.33a±0.58
Ethanolic 12.67cd±0.58 13.67bc±1.15 14.33b±1.52 11.33a±1.15
P. guajava Aqueous 14.33de±1.15 13.33bc±0.58 17.33c±1.15 13.33a±0.58
Ethanolic 18.33f±0.58 17.33d±1.15 17.00c±1.00 17.67c±1.15
Standard 24.33a±1.153 27.33f±1.15 27.33f±1.15 22.00d±1.00
According to table 3, the inhibition diameter for the aqueous plant extracts for all the microbial
the aqueous extracts of the leaf extracts of the isolates studied (Table 3).
plants against Candida albican ranged from
For the ethanolic leaf extracts of the plants, the
8.33±0.58mm in T.catappa to 14.33±1.15mm in
inhibition diameter of the plants against C.
P. guajava. For the aqueous leaf extract of the
albican ranged from 12.67±0.58mm by T.
plants against Klebsiella pneumonia, the
catappa to 18.33±0.58 in P. guajava. K.
inhibition diameter varied from 8.67±0.58 mm
pneumonia, the diameter of inhibition for the
in T. catappa to 15.67±2.52mm in G. latifolium.
ethanolic leaf extracts of the plants ranged from
The aqueous leaf extracts of the plants against
13.33±0.58 mm in T. catappa to 24.00±2.00mm
E. coli ranged from 11.33±0.58mm in T.
in G. latifolium. The inhibition diameter by the
catappa to 17.33±1.15 in P. guajava. For
ethanolic leaf extracts of the plants against E.
Bacillus subtilis, the inhibition diameter by the
coli ranged from 14.33±1.52mm in T. catappa
aqueous leaf extracts of the plants ranged from
to 22.33±1.53mm in G. latifolium. For Bacillus
11.33±1.15mm by T.catappa to 13.33±0.58mm
subtilis, the diameter of inhibition by the
in P. guajava. The diameter of inhibition for all
ethanolic leaf extracts of the plants varied from
the aqueous leaf extracts of the plants studied
11.33±1.15mm in T. catappa to 19.33±1.33mm
were least in T. catappa. Apart from K.
in G. latifolium. The diameter of inhibition was
pneumonia, P. guajava showed the highest
least in T.catappa for all the microorganisms
diameter of inhibition for all the
studied while G. latifolium showed the highest
microorganisms considered. This shows that the
diameter of inhibition for all the clinical isolates
aqueous leaf extract of P. guajava is more
investigated. This shows that the ethanolic leaf
potent compared to the aqueous leaf extract of
extract of G. latifolium is more potent compared
the other plant species for the microbial isolates
to the leaf extracts of the other plants considered.
studied. None of the microorganisms showed
The pathogens were more susceptible to the
resistance to the aqueous leaf extracts of the
standard antibiotics (Gentamycin) relative to the
plants. The standard antibiotic (Gentamycin)
leaf extracts of the plant studied.
showed higher diameter of inhibition relative to
Table4. Minimum inhibitory concentration of Candida albican
Samples Organism/ Extract 200ml 150ml 100ml 50ml Remark (MIC)
P. guineensesAqueous 10.67±0.32 9.33±0.15 0.00±0.00 0.00±0.00 150mg/ml
Ethanolic 12.33±0.58 9.67±0.48 0.00±0.00 0.00±0.00 150mg/ml
G.latifolium Aqueous 12.33±0.67 9.67±56 0.00±0.00 0.00±0.00 150mg/ml
Ethanolic 16.33±1.00 15.67±1.00 0.00±0.00 0.00±0.00 150mg/ml
T. catappa Aqueuos 8.33±0.21 0.00±0.00 0.00±0.00 0.00±0.00 200mg/ml
Ethanolic 11.67±0.32 8.33±0.48 0.00±0.00 0.00±0.00 150mg/ml
P. guajava Aqueous 15.33±0.12 12.00±0.56 10.00±0.58 0.00±0.00 100mg/ml
Ethanolic 18.00±0.67 14.67±0.32 13.67±0.29 0.00±0.00 100mg/ml
Table 4 presents the minimum inhibition For the ethanolic leaf extracts of the plants
concentration of Candida albican. Apart from studied, apart from P. guajava that inhibited
the aqueous leaf extract of P. guajava that Candida albican at concentration of 100ml with
inhibited Candida albican at 100ml with diameter of inhibition of 13.67±0.29 mm, the
diameter of inhibition of 13.67±0.29mm, all the ethanolic leaf extracts of the other plants
other ethanolic leaf extracts of the plants inhibited the microorganisms at concentration of
inhibited C. albican at 150ml. 150ml.
22 International Journal of Research in Pharmacy and Biosciences V5 ● I2 ● 2018
Phytochemical Screening and Antimicrobial Activity of Four Nigerian Medicinal Plants
Table5. Minimum inhibitory concentration of Klebsiella pneumoniae
Samples Organism/ Extract 200ml 150ml 100ml 50ml Remark (MIC)
P. guineenses Aqueous 9.33±0.29 0.00±0.00 0.00±0.00 0.00±0.00 200mg/ml
Ethanolic 15.00±0.67 10.67±0.32 0.00±0.00 0.00±0.00 150mg/ml
G. Latifolium Aqueous 16.67±1.15 11.67±0.29 0.00±0.00 0.00±0.00 100mg/ml
Ethanolic 22.33±0.32 17.67±0.56 14.00±0.32 0.00±0.00 100mg/ml
T. catappa Aqueous 8.67±0.48 0.00±0.00 0.000.00 0.00±0.00 200mg/ml
Ethanolic 12.33±0.56 10.00±0.58 0.00±0.00 0.00±0.00 150mg/ml
P. guajava Aqueous 16.33±0.58 13.00±0.29 8.33±0.56 0.00±0.00 100mg/ml
Ethanolic 20.00±0.67 19.67±1.15 17.33±0.58 0.00±0.00 100mg/ml
Table 5 shows the minimum inhibition pneumonia at concentration of 150ml with
concentration of Klebsiella pneumonia by the diameter of inhibition of 11.67±0.29mm. For the
ethanolic leaf extracts of the plants studied. ethanolic leaf extracts of the plants considered,
Aqueous leaf extracts of P guajava inhibited the G. latifolium and P. guajava inhibited Klebsiella
microorganism at concentration of 100ml. P. pneumonia at concentration of 150ml. This
guineenses and T.catappa inhibitedKlebsiella shows that K. pneumonia was more sensitive to
pneumonia at concentration of 200ml. The G. latifolium and P. guajava compared to P.
aqueous leaf extract of G. latifolium inhibited K. guineenses and T.catappa
Table6. Minimum Inhibitory concentration of E. coli
Samples Organism/Extract 200ml 150ml 100ml 50ml Remark (MIC)
P. guineenses Aqueous 17.67±1.15 13.67±0.48 9.67±0.29 0.00±0.00 100mg/ml
Ethanolic 21.33±0.67 19.00±1.15 13.67±0.48 0.00±0.00 100mg/ml
G. latifolium Aqueous 14.33±0.56 11.67±0.56 0.00±0.00 0.00±0.00 150mg/ml
Ethanolic 21.33±0.29 17.67±0.32 14.67±0.56 0.00±0.00 100mg/ml
T. catappa Aqueous 10.67±0.58 8.00±0.29 0.00±0.00 0.00±0.00 150mg/ml
Ethanolic 16.67±0.48 13.33±0.56 0.00±0.00 0.00±0.00 100mg/ml
P. guajava Aqueous 19.67±0.67 15.67±0.48 12.00±0.32 0.00±0.00 100mg/ml
Ethanolic 20.67±0.56 18.33±0.67 15.33±0.58 0.00±0.00 100mg/ml
Table 6 shows the minimum inhibition susceptible to the aqueous leaf extracts of P.
concentration of E. coli by the leaf extracts of guineenses and P. guajava compared to G.
the plant species investigated. Aqueous leaf latifolium and T. catappa. For the ethanolic leaf
extracts of P. guineenses and P. guajava extracts of the plants studied, apart from T.
inhibited E. coli at concentration of 100ml, catappa that inhibited E. coli at a concentration
while G.latifolium and T. catappa inhibited the of 150ml, the ethanolic leaf extract of the other
microorganisms at a minimum concentration of plants inhibited the clinical isolates at a
150ml. This shows that E. coli is more concentration of 100ml.
Table7. Minimum Inhibitory concentration of Bacillus subtilis
Samples Organism/Extract 200ml 150ml 100ml 50ml Remark (MIC)
P. guineensesAqueous 11.67±0.29 8.67±0.32 0.00±0.00 0.00±0.00 150mg/ml
Ethanolic 17.33±0.56 14.00±1.00 12.00±0.56 0.00±0.00 100mg/ml
G. latifolium Aqueous 12.00±0.58 8.67±0.29 0.00±0.00 0.00±0.00 150mg/ml
Ethanolic 19.00±0.67 14.67±0.56 11.33±0.48 0.00±0.00 100mg/ml
T. catappa Aqueous 10.67±0.48 9.33±0.1.15 0.00±0.00 0.00±0.00 150mg/ml
Ethanolic 16.00±0.32 11.67±0.58 0.00±0.00 0.00±0.00 150mg/ml
P. guajava Aqueous 11.67±0.56 10.33±0.67 0.00±0.00 0.00±0.00 150mg/ml
Ethanolic 16.67±1,15 12.33±0.48 11.67±0.32 0.00±0.00 100mg/ml
Table 7 shows the minimum inhibition isolate at 150ml, the ethanolic extracts of all the
concentration of Bacillus subtilis by the leaf plants inhibited Bacillus subtilis at the
extracts of the plants studied. The aqueous leaf concentration of 100ml.
extract of all the plants inhibited Bacillus
DISCUSSION
subtilis at a concentration of 150ml. For the
ethanolic leaf extracts of the plants considered, The susceptibility of the test microorganisms is
apart from T. catappa that inhibited the clinical related to the inhibition zone size in millimetres
International Journal of Research in Pharmacy and Biosciences V5 ● I2● 2018 23
Phytochemical Screening and Antimicrobial Activity of Four Nigerian Medicinal Plants
via agar well diffusion assay. The ingredients. This may justify the traditional use
phytochemical screening conducted on the plant of alcohol in extracting the leaf component of
extracts revealed the presence of chemical the medicinal plants from application against
constituents which has been shown to possess pathogens (Panditt and Langfield 2004).
some pharmacological activities (Trease and
The ethanol extracts demonstrated a higher
Evans 1989). The analysis of the plant extracts
activity than the aqueous extract in leaf sample.
revealed the presence of phytochemicals such as
The better efficacy of the ethanol extract as
alkaloids, saponins, tannins, phenols and
against the aqueous extracts may be because
flavonoids. Alkaloids in these plants can be
different solvent have different polarities hence
efficient therapeutically. Pure isolated plant
different degree of solubility (Doughri 2007).
alkaloids and their synthetic derivatives are used
Based on the limited effect of activity of the
as basic medicinal agents for their analgesic,
other extracts compared with the ethanol
antispasmodic and bacterial effect (Stray 1998).
extracts, it suggests that the active component is
Alkaloids isolated from Ruta graveolens L.
more soluble in ethanol than in the aqueous
leaves have fungicidal activity against Fusarium
extracts.
species (Oliva et al 2003). Pharmacological
activities have been reported about saponins However Doughri (2007) stated that the
such as antibiotics, antifungal, antiviral, antimicrobial effect of these plants could be due
hepatoprotective anti-inflammatory and anti- to the bioactive compounds such as the
ulcer (Oakenfull 1986). Tannins are basically phytochemical constituent present in the plants.
used for the treatment of inflammation, The level of inhibition of the pathogen by the
leucorrhoea, gonorrhoea, burn, piles and test extracts shows the extracts to be appreciably
diarrhea (Buzzini et al.2008). They are also used
potent. Generally, the activity of plant extracts
for tannin of animal hides to convert them to
leather. Phenols are very wide spread in nature. against disease causing microorganisms and
their use in traditional remedies is considered to
They range from simple structures having a be a function of the phytochemicals in the plants
simple aromatic ring to highly complex (Sofawara 1993). These bioactive compounds
polymeric structures and often exist in
are known to act by different mechanism and
glycosidic forms (Williamson and Manach
exert antimicrobial action. Tannins bind to
2005). Capsacin is formed in the dried ripe fruit
of different species of capsicum. It has been proline rich proteins and interfere with the
used internally for dyspepsia and flatulence. protein synthesis (Shimada 2006)
Externally, it is frequently used as counter REFERENCES
irritant (Mattila and Hellstrom 2001).
Flavonoids are plant nutrients that when [1] Adeyemi O. S., Akanji M.A., Oguntoye S.A.
(2009). Ethanolic leaf extract of Psidium
consumed in the form of fruits and vegetables guajava: Phyto-chemical and trypanocidal
are non-toxic as well as potentially beneficial to activity in rats infected with Trypanosoma
the human body; up till now, more than 200 brucei. J Med Plants Res.3:420–3.
different flavonoids have been isolated from [2] Akinyemi K. O., Coker, A. O., Bayagbon C.,
vegetables (Taiz and Ziegler 2006) Oyefolu, A. O. B., Akinsinde, K. A. and
It was observed that at little concentrations of Omonigbelin, E. O. (2000). Antibacterial
50ml, there was little or no visible growth or screening of five Nigerian medicinal plants
inhibition shown on the sterile petri dishes against S. typhi and S. paratyphi. Journal of
Nigeria. Inf. Cont. 3(1).
which formed the minimum inhibition
concentration (MIC); but the concentration of [3] Anyanwu C. U. and Nwosu G. C. (2014).
200ml showed the highest visible inhibition of Assessment of the antimicrobial activity of
aqueous and ethanolic extracts of Piper
the microorganisms than 150 and 100ml. This
guineense leaves, Journal of Medicinal Plant
micro dilution method has provided a Research, Vol.8(10): 337-439
potentially useful technique for quantitative
[4] Arima H., Danno G. (2002). Isolation of
antibacterial assays (Ncube 2007)
antimicrobial compounds from guava (Psidium
Ethanol has been shown to be a stronger guajava L.) and their structural elucidation. Bio
extractant than water (Brain and Turner 1975, sci Biotechnol Biochem.66:1727–30.
Akinyemi 2000). The presence of ethanol in [5] Ashok K. and Upadhyaya K. (2012), Tannins
addition to achieving better extraction may also are Astringent, Journal of Pharmacognosy and
enhance the efficacy of the active principle or Phytochemistry, IC Journal, 3 (1) 49.
24 International Journal of Research in Pharmacy and Biosciences V5 ● I2 ● 2018
Phytochemical Screening and Antimicrobial Activity of Four Nigerian Medicinal Plants
[6] Barbalho S. M, Farinazzi-Machado F.M., de [20] Harborne J. B. (1988). Introduction of
Alvares Goulart R., Brunnati A.C., Ottoboni ecological Biochemistry. 3rd edition. Academic
A.M. (2012). Psidium guajava (Guava) A plant Press. Pp. 2.
of multipurpose medicinal plants. Med Aromat [21] Joseph B. and Priya M. (2011). Review on
Plants, 1:104. nutritional, medicinal, and pharmacological
[7] Brain K.R. and Turner I. D. (1975). Basic properties of guava (Psidium Guajava Linn.)
medical microbiology. 2nd edition. Little Brown Int J Pharma Bio Sci.2:53–69.
and Company. Boston. [22] Joseph B., Priya R. M, Helen P. A and Sujatha
[8] Bruneton J. (1999). Pharmacognosy, Phyto S. (2010). Bio-active compounds in essential
chemistry, Medicinal Plants. Second Edition. oil and its effects of antimicrobial, cytotoxic
Lavoisier Publishing, France.p. 1119. activity from the Psidium Guajava (L.) leaf. J
[9] Buzzini P., Arapitsas P., Goretti M., Brand E., Adv Biotechnol. 9:10–4.
Turchehtti B., Pirielli P., Lert F. and Romani A. [23] Joseph B. and Priya R. M. (2011).
(2008). Antimicrobial and antiviral activity of Phytochemical and biopharmaceutical aspects
hydrolysable tannins Mini. Rev. Med. Chem., 8: of Psidium guajava (L.) essential oil: A review.
1178 – 1179 Res J Med Plant.5:432–42.
[10] Corlett A (2009). A Checklist of the Total [24] Kamath J. V., Rahul N. (2008). Ashok Kumar
Vascular Plant Flora of Singapore: Native, CK, Lakshmi SM. Psidium guajava L.: A
Naturalised and Cultivated Species. Raffles review. Int J Green Pharm.2:9–12.
Museum of Biodiversity Research, National [25] Kumar A. (2012). Importance for life ‘Psidium
University of Singapo re, Singapore. 273 pp. guajava’Int J Res Pharm Biomed Sci.3:137–3.
[11] Cowan M. M. (1999). Plant Products as [26] Mamta S. M., Saxena J., Nema R., Singh D.
Antimicorbial Agents. Clin. Microbial Rev. and Gupta A. (2013), Phytochemistry of
12:564- 582. Medicinal Plants, Journal of Pharmacognosy
[12] Dada A. A., Ifesan B. O. T. and Fashakin J. F. and Phytochemistry, 1 (6): 177.
(2013), Antimicrobial And Antioxidant [27] Mattila P. and Hellstrom J. (2001). Phenolic
Properties Of Selected Local Spices Used In acids in potatoes, vegetable and some of their
“Kunun” Beverage In Nigeria, Acta Sci. Pol., products. J. Food Compos Anal., 20:152 – 160
Technol. Alignment, 12 (4): 374
[13] Doughri J. H., El-Mahmud A. M. and Manzara [28] Metwally A. M, Omar A. A, Harraz F. M and
S. (2007). Studies on the antibacterial activities El Sohafy S. M. (2010). Phytochemical
of root extract of Caricapapaya L. African investigation and antimicrobial activity of
Journal Microbiology Research, 303-310. Psidium guajava L. leaves. Pharmacogn
[14] Edet U.U., Ehiabhi, O. S., Ogunwande I.A., Mag.6:212–8.
Walker T.M., Schmidt J.M., Setzer W.N., [29] Mittal P., Gupta V., Kaur G., Garg A. K., Singh
Ogunbinu A.O. and Ekundayo O.(2005). A. (2010).Phytochemistry and pharmacological
Analyses of the volatile constituents and activitiesof Psidium guajava: A review. Int J
antimicrobial activities of Gongronema Pharm Sci Res. 1:9–19.
latifolium Benthand Gnetum africanum L.
Journal of Essential Oil-Bearing Plants, 8(3): [30] Morebise O., Fafunso M. A., Makinde J. M.,
324–329. Olajide O. A and Awe E. O. (2002). Anti
inflamatory property of the leaves of
[15] Eleyinmi, A.F.(2007). Chemical composition
Gongronema latifolium. Phytother Res. 16(1):
and antibacterial activity of Gongronema
S75–S77.
latifolium. Journal of Zhejiang University,
Science B, 8(5): 352–358. [31] Morebise O., Fafunso M. A. (1998).
[16] Essien, J. P., Ebong, G. A. and Akpan, E. Antimicrobial and phytotoxic activities of
J.(2007). Antioxidant and antitussive properties saponin extracts from two Nigerian edible
of Gongronema latifolium leaves used locally medicinal plants. Biokemistri 8(2):69–77.
for the treatment of fowl cough in Nigeria [32] Nagappa, A.N., Thakurdesai, P.A. Rao N.V.
[17] Gashe F, Belete A, Gebre-Mariam T. (2010). and Singh J. (2003). Antidiabetic activity of
Evaluation of antimicrobial and anti-inflam Terminalia catappa Linn fruits. Journal of
matory activities and formulation studies on the ethno pharmacology, 88(1): 45-50.
leaf extracts of Psidium guajava L. Ethiop [33] Ncube N. S. Afolayan A. J. and Okoh A. I.
Pharm J. 28:131–42. (2007). Assessment techniques of antimicrobial
[18] Gupta G. K., Chahal J and Arora D. (2011). properties of natural compounds of plant origin:
Psidium guajava Linn. Current research and current methods and future trends. Afr. J.
future prospects. J Pharm Res.4:42–6. Biotechnol. (7): 1797 – 1806.
[19] Harborne J. B. (1973). Phytochemical Methods. [34] Nwachukwu C. U., Ume N. C., Obasi M. N.,
Chapman and Hall Ltd. London. Pp 11-113. Nzewuihe G. U. and Onyirioha C. (2010), The
International Journal of Research in Pharmacy and Biosciences V5 ● I2● 2018 25
Phytochemical Screening and Antimicrobial Activity of Four Nigerian Medicinal Plants
Qualitative Uses Of Some Medicinal Plants In [47] Schneider C., Rotscheidt K., Breitmaier E.
Ikeduru L.G.A Of Imo State, Nigeria, New York (1993). 4 new pregnane glycosides from
Science Journal, issue 3 (11): 132. Gongronema latifolium (Asckepiadaceae)
Liebigs Annalen Der Chemie.10:1057–1062.
[35] Oakenfull, D. G. (1986). Aggregation of bile
acids and saponins in aqueous solution, Austr. [48] Shimada T. (2006). Salivary proteins as a
J. Chem., 39: 1671 – 1683. defense against dietary tannins. J. Chem. Ecol.
32 (6): 1149-1163.
[36] Obadoni B. O., Ochuku P. O. (2001).
Phytochemical Studies and Comparative [49] Sofawara A (1993). Medicinal Plants and
Efficacy of the Crude Extracts of Some Traditional Medicine in Africa. Spectrum
books Ltd, Ibadan Nigeria. Pp 191-289.
Homeostatic Plants in Edo and Delta states in
Nigeria. Global Journal of Pure Applied [50] Stray F. (1998). The natural guide to medicinal
Science7(3): 455 – 459 herbs and plants. Tiger Books international
London, Pp. 12 – 16
[37] Ogundipe O. O, Moody J. O, Akinyemi T. O.
(2003). Raman A. Hypoglycemic potentials of [51] Sumathykutty M. A, Rao J. M., Padmakumari
methanolic extracts of selected plant foods in K. P., Narayanan C. S. (1999). Essential Oil
Constituents of Some Piper Species, Flavors
alloxanized mice. Plant Foods Hum Nutr.
Fragr. Journal, 14: 280-281.
58(3):1–7.
[52] Taiz L. and Ziegler E. (2006). Plant
[38] Okeke E.C., Eneobong H.N., Uzuegbunam A.
physiological, 4th edn. Ch. 13. Pp. 315 – 344.
O., Ozioko A. O. and Kuhnlein H.(2008). Igbo Sinauer Associates, Publishers, Massam
traditional food system: documentation, uses chusetts
and research needs. Pakistan Journal of
[53] Tan H.T.W. (2011). Sea almond Terminalia
Nutrition7(2): 365–376.
catappa. Pp. 447. In: Ng, P.K.L., R.T. Corlett
[39] Oshinubi R.A. and Awodele O.(2006). The &H.T.W. Tan (editors), Singapore Biodiversity.
effect of ethanolic stem extract of Gongronema An encyclopedia of the natural environment
latifolium on blood glucose of normal and and sustainable development, Editions Didier
alloxan induced diabetic rabbits. Nigerian Millet, Singapore, 552 pp.
Journal of Health and Biomedical Sciences 5 [54] Tona L., Kambu K., Ntondele D., Cimanga K.,
(2): 39–44. Luki N.(1994) Antimicrobial activity of
[40] Oliva A. Meepagala K., Wedge D., Harries D., tannins. Fitoterapia. 65:276–8.
Hale A., Alliota G. and Duke S. (2003). Natural [55] Trease G. E., Evans W. C. (1989).
fungicides from Ruta graveolensL. leaves, Pharmacognsy 11th edn. Braillain Tiridel Can.
including a new quinolone alkaloid. J. Agric Macmillian Publishers.
Food Chem., 51: 890 – 896
[56] Tyler V. (1994). Phytomedicines in Western
[41] Pal D. and Verma P. (2013). Flavonoids: A Europe: their potential impact on herbal
Powerful and Abundant Source Of medicine in the United States Herbalgram; 30:
Antioxidants, International Journal of 24-30.
Pharmacy and Pharmaceutical Sciences, Vol. [57] Ugochukwu N. H, Babady N. E, Cobourne M.,
5, Issue 3, p.97. Gasset S. R. (2003).The effect of Gongronema
[42] Panditt K. and Langfield R. D. (2004). latifolium leaf extract on serum lipid profile and
Antibacterial activity of some Italian medicinal oxidative stress of hepatocytes of diabeticrats. J
plants. Journal of Ethanopharmacology, Biosci. 28:1–5.
82:135-142. [58] Ugochukwu N. H and Babady N. E. (2002).
[43] Perez C., Paul M., and Bazerque P. (1990). Antioxidant effects of Gongronema latifolium
Antibiotic Assay by Agar Well diffusion in hepatocytesof ratmodels of non-insulin
Method. Acta Bio. Med. Exp. 15:113-115. dependent diabetes mellitus. Fitoterapia. 73(7-
8):612–618.
[44] Prabu G. R, Gnanamani A, Sadulla S. (2006).
Guaijaverin: A plant flavonoid as potential [59] Ugochukwu N. H. and Babady N. E. (2003).
antiplaqueagent against Streptococcus mutans. Antihyperglycemic effect of aqueous and
J Appl Microbiol.101:487–95 ethanolic extracts of Gongronema latifolium
leaves on glucose and glycogen metabolism in
[45] Ratnasooriya W.D. andDharmasiriM.G. (2000). livers of normal and streptozotocin-induced
Effects of Terminalia catappa seeds on sexual diabetic rats. Life Sciences 73(15): 1925–1938.
behavior and fertility of male rats. Asian
[60] Ugochukwu N. H. and Cobourne M. K.(2003).
Journal of Andrology, 2: 213-219. Modification of renal oxidative stress and lipid
[46] Rishika D. and Sharma R. (2012). An update of peroxidation in streptozotocin-induced diabetic
pharmacological activity of Psidium guajava in rats treated with extracts from Gongronema
the management of various disorders. Int J latifolium leaves. Clinica Chimica Acta 336(1–
Pharm Sci Res. 3:3577–84. 2): 73–81.
26 International Journal of Research in Pharmacy and Biosciences V5 ● I2 ● 2018
Phytochemical Screening and Antimicrobial Activity of Four Nigerian Medicinal Plants
[61] Ushimaru P. I, Silva M. T, Di Stasi L. C, [63] Williamson G. and Manach C. (2005).
Barbosa L., Fernandes A. (2007). Antibacterial Bioavailability and bioefficacy of polyphenols
activity of medicinal plant extracts. Braz J in humans. 11.Review of a3 intervention
Microbiol. 38:717–9. studies. Am. J. Clin. Nutr. 81 (1): 243 – 255.
[62] Van-Burden T.P, Robinson W.C. (1981). [64] Yadav R. N. and Agarwala M. (2011).
Formation of complexes between protein and Phytochemical analysis of some medicinal
tannin acid. J. Agric food Chem., 1:77. plants. J. Phytology 3(12)
Citation: Nduche M.U et. al " Phytochemical Screening and Antimicrobial Activity of Four Nigerian
Medicinal Plants ", International Journal of Research in Pharmacy and Biosciences, vol. 5, no. 2, pp. 15-27,
2018.
Copyright: © 2018 Nduche M.U. This is an open-access article distributed under the terms of the
Creative Commons Attribution License, which permits unrestricted use, distribution, and reproduction in
any medium, provided the original author and source are credited.
International Journal of Research in Pharmacy and Biosciences V5 ● I2● 2018 27
You might also like
- Qualitative and Quantitative Phytochemical AnalysiNo ratings yetQualitative and Quantitative Phytochemical Analysi4 pages
- Edited - Qualitative and Quantitative Phytochemical Analysis of Gongronema LatifoliumNo ratings yetEdited - Qualitative and Quantitative Phytochemical Analysis of Gongronema Latifolium4 pages
- Phytochemical Analysis of Gongronema LeafNo ratings yetPhytochemical Analysis of Gongronema Leaf9 pages
- Plants That Have Antimicrobial and Their PhtochemicalsNo ratings yetPlants That Have Antimicrobial and Their Phtochemicals18 pages
- Phytochemical Analysis of Piper guineense LeavesNo ratings yetPhytochemical Analysis of Piper guineense Leaves5 pages
- Edible Plants and Their Uses in NigeriaNo ratings yetEdible Plants and Their Uses in Nigeria12 pages
- Antimicrobial Properties of Nigerian PlantsNo ratings yetAntimicrobial Properties of Nigerian Plants46 pages
- Comparative Study of The Phytochemical and Antibacterial Activity of Leaf Extracts of Euphorbia Heterophylla and Vitellaria ParadoxaNo ratings yetComparative Study of The Phytochemical and Antibacterial Activity of Leaf Extracts of Euphorbia Heterophylla and Vitellaria Paradoxa9 pages
- Nutritional Benefits of Aju Mbaise Herbal CocktailNo ratings yetNutritional Benefits of Aju Mbaise Herbal Cocktail18 pages
- Antimicrobial - Studies - and - Phytochemical Analysis of The Fruits and Leaves of Cnestis FerrugineaNo ratings yetAntimicrobial - Studies - and - Phytochemical Analysis of The Fruits and Leaves of Cnestis Ferruginea11 pages
- Antibacterial Activity of Medicinal Plants in GhanaNo ratings yetAntibacterial Activity of Medicinal Plants in Ghana8 pages
- Antibacterial, Phytochemical and Antioxidant Activities of The Leaf Extracts of Gliricidia Sepium and Spathodea CampanulataNo ratings yetAntibacterial, Phytochemical and Antioxidant Activities of The Leaf Extracts of Gliricidia Sepium and Spathodea Campanulata8 pages
- Antimicrobial Properties of Gmelina Arborea ExtractNo ratings yetAntimicrobial Properties of Gmelina Arborea Extract14 pages
- Phytochemical and Nutrient Evaluation of The Leaves and Fruits ofNo ratings yetPhytochemical and Nutrient Evaluation of The Leaves and Fruits of17 pages
- Antimicrobial Effects of Terminalia catappa ExtractsNo ratings yetAntimicrobial Effects of Terminalia catappa Extracts5 pages
- Antiplasmodial Effects of Acacia niloticaNo ratings yetAntiplasmodial Effects of Acacia nilotica7 pages
- Phytochemical Analysis of Garhwal PlantsNo ratings yetPhytochemical Analysis of Garhwal Plants4 pages
- Antibacterial Properties of Irvingia GabonensisNo ratings yetAntibacterial Properties of Irvingia Gabonensis35 pages
- The Journal of Phytopharmacology: Spiropetalum HeterophyllumNo ratings yetThe Journal of Phytopharmacology: Spiropetalum Heterophyllum1 page
- Sida Acuta Burm. F. A Medicinal Plant With Numerous PotenciesNo ratings yetSida Acuta Burm. F. A Medicinal Plant With Numerous Potencies7 pages
- Moringa Oleifera Seed Analysis: Phytochemicals & AntimicrobialsNo ratings yetMoringa Oleifera Seed Analysis: Phytochemicals & Antimicrobials12 pages
- The Effectof Gongronema Latifolum Utazion Some Haematological Parametersof RabbitNo ratings yetThe Effectof Gongronema Latifolum Utazion Some Haematological Parametersof Rabbit10 pages
- Phytochemical and Toxicity Study of Meliosma pinnataNo ratings yetPhytochemical and Toxicity Study of Meliosma pinnata29 pages
- Antimicrobial Properties of Eucalyptus and GuavaNo ratings yetAntimicrobial Properties of Eucalyptus and Guava21 pages
- Medicinal Plants in Nigerian Herbal MedicineNo ratings yetMedicinal Plants in Nigerian Herbal Medicine12 pages
- Antimicrobial Activity of Carica Papaya (Pawpaw Leaf) On Some PatNo ratings yetAntimicrobial Activity of Carica Papaya (Pawpaw Leaf) On Some Pat13 pages
- Antimicrobial Activity of Medicinal PlantsNo ratings yetAntimicrobial Activity of Medicinal Plants6 pages
- Antibacterial Effects of Avocado Leaf ExtractNo ratings yetAntibacterial Effects of Avocado Leaf Extract6 pages
- Antibacterial Effects of Moringa ExtractsNo ratings yetAntibacterial Effects of Moringa Extracts3 pages
- Ethnotherapeutics of Medicinal Plants in Eastern NigeriaNo ratings yetEthnotherapeutics of Medicinal Plants in Eastern Nigeria9 pages
- Antioxidant & Antimicrobial Study of Microdesmis puberulaNo ratings yetAntioxidant & Antimicrobial Study of Microdesmis puberula11 pages
- Anti-Inflammatory Study of Naregamia AlataNo ratings yetAnti-Inflammatory Study of Naregamia Alata6 pages
- Medicinal Plants Against Malaria: InnovationsNo ratings yetMedicinal Plants Against Malaria: Innovations5 pages
- Guiera senegalensis: Phytochemicals & SafetyNo ratings yetGuiera senegalensis: Phytochemicals & Safety4 pages
- Antibacterial and Phytochemical Analysis of Aju MbaiseNo ratings yetAntibacterial and Phytochemical Analysis of Aju Mbaise45 pages
- Preliminary Study of The Antibacterial and Analgesic Effect of The Leaf Extract of Pterocarpus Santalinoides L'Hér. Ex DCNo ratings yetPreliminary Study of The Antibacterial and Analgesic Effect of The Leaf Extract of Pterocarpus Santalinoides L'Hér. Ex DC6 pages
- Activity-Guided Isolation and GC-MS AnalyticalNo ratings yetActivity-Guided Isolation and GC-MS Analytical17 pages
- Health Benefits of Bitter Leaf in NigeriaNo ratings yetHealth Benefits of Bitter Leaf in Nigeria17 pages
- Health Benefits of Bitterleaf & Scent LeafNo ratings yetHealth Benefits of Bitterleaf & Scent Leaf22 pages
- User Programmable Battery Charger SystemNo ratings yetUser Programmable Battery Charger System5 pages
- Hepadnaviridae With A Very High Transmissibility (Dienstag and Isselbacher, 2005) - ThisNo ratings yetHepadnaviridae With A Very High Transmissibility (Dienstag and Isselbacher, 2005) - This4 pages
- Gi-Fi: Next-Gen Gigabit Wireless TechnologyNo ratings yetGi-Fi: Next-Gen Gigabit Wireless Technology8 pages
- Boron Neutron Capture Therapy For Breast CancerNo ratings yetBoron Neutron Capture Therapy For Breast Cancer2 pages
- Taxation's Role in Nigeria's TransformationNo ratings yetTaxation's Role in Nigeria's Transformation11 pages
- Impact of PH Balance On Environment 2020No ratings yetImpact of PH Balance On Environment 202014 pages
- Food Microbiology and Preservation TechniquesNo ratings yetFood Microbiology and Preservation Techniques28 pages
- Western Australian Honey Research InsightsNo ratings yetWestern Australian Honey Research Insights12 pages
- MCB 314: Understanding BiodeteriorationNo ratings yetMCB 314: Understanding Biodeterioration20 pages
- Redefining Women's Underwear - SilverTech by Organic Basics - KickstarterNo ratings yetRedefining Women's Underwear - SilverTech by Organic Basics - Kickstarter1 page
- Synthesis and Activity of Pyrimidine DerivativesNo ratings yetSynthesis and Activity of Pyrimidine Derivatives8 pages
- PhEur 5.1.4. Micro Quality of Pharmaceutical PreparationsNo ratings yetPhEur 5.1.4. Micro Quality of Pharmaceutical Preparations2 pages
- Lemon and Baking Soda Miraculous Combination100% (8)Lemon and Baking Soda Miraculous Combination14 pages
- Introduction to Microbiology Study GuideNo ratings yetIntroduction to Microbiology Study Guide25 pages
- Antimicrobial Susceptibility Testing - BIOMAXIMA - Ulotka - Lekowrażliwość - A4 - PrevNo ratings yetAntimicrobial Susceptibility Testing - BIOMAXIMA - Ulotka - Lekowrażliwość - A4 - Prev8 pages
- Negin Ehyaeirad, Nima Babolanimogadam, Masoomeh Dadkhah, Leila Rezaie ShirmardNo ratings yetNegin Ehyaeirad, Nima Babolanimogadam, Masoomeh Dadkhah, Leila Rezaie Shirmard11 pages
- TDSEN SYNGUARD BG20I สารfinishing กันแบค เสื้อNo ratings yetTDSEN SYNGUARD BG20I สารfinishing กันแบค เสื้อ3 pages
- SOP For Antimicrobial Effectiveness TestingNo ratings yetSOP For Antimicrobial Effectiveness Testing5 pages
- Evaluation of Local Disinfectants' Antibacterial ActivityNo ratings yetEvaluation of Local Disinfectants' Antibacterial Activity51 pages
- Cleaning Validation and Facility Cleaning Regulatory TrendsNo ratings yetCleaning Validation and Facility Cleaning Regulatory Trends52 pages
- 1111 - USP Micro Limit Test For Non Sterile100% (1)1111 - USP Micro Limit Test For Non Sterile2 pages
- Antimicrobial Effects of Garlic (Allium Sativum L.)No ratings yetAntimicrobial Effects of Garlic (Allium Sativum L.)5 pages
- STERIS Spor Klenz Ready To Use Cold Sterilant TDS 420 100 6525ANo ratings yetSTERIS Spor Klenz Ready To Use Cold Sterilant TDS 420 100 6525A4 pages